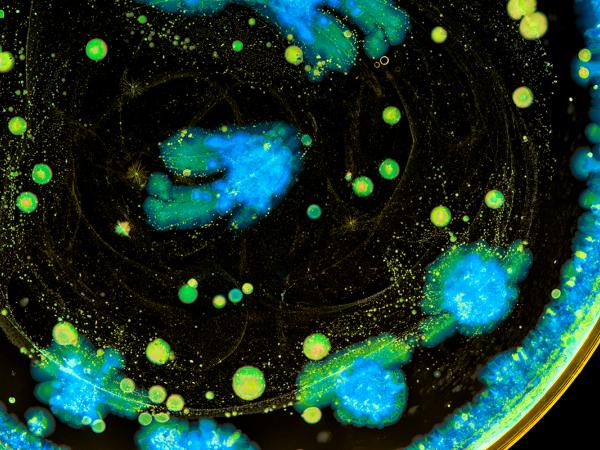

Mintz Guides Spero to Another Follow-On Public Offering

Key Facts
- Mintz represented Spero Therapeutics in its September 2020 underwritten public offering
- Spero's gross proceeds were $80 million prior to the deduction of any underwriting discounts and commissions
- Mintz partners with emerging growth companies like Spero to help them thrive in the marketplace
The Situation
Mintz had previously represented Spero Therapeutics, a multi-asset clinical-stage biopharmaceutical company, in its $77 million initial public offering (IPO), its July 2018 $75 million underwritten public offering, its $10 million registered direct offering in June 2019, and its $30 million, fully backstopped rights offering in February 2020.
The Approach
The public offering includes 4,785,000 shares of Spero’s common stock and 3,215,000 shares of Spero’s non-voting Series D Convertible Preferred Stock. Spero’s gross proceeds were $80 million prior to the deduction of any underwriting discounts and commissions.
The Outcome
Our team’s work with Spero Therapeutics demonstrates how we partner with emerging growth clients to help them gain access to and succeed in the public market.
Supporting Professionals
The Mintz team, led by Lewis Geffen and Matthew Gardella, included Matthew Tikonoff, Samantha Silver, Josh Bergmann, Linda Bentley, and Roy Gillig.
More Case Studies